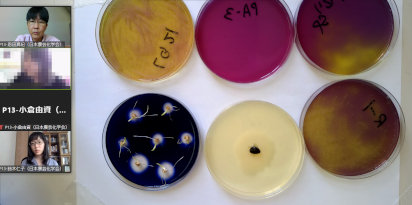

女子中高生夏の学校2022
「女子中高生夏の学校2022〜科学・技術・人との出会い〜」
女子中高生の理系進学支援を目的とし、科学技術振興機構(JST)をはじめ多くの団体・学協会が支援してきた上記イベント(愛称:夏学)が、今年も8月7日から8月8日まで実施された(主催:NPO法人女子中高生理工系キャリアパスプロジェクト、後援:文部科学省、経団連、他18団体)。2019年までは、100名超の女子中高生が2泊3日の合宿を通して実験やキャリアプラニングを体験する形式であったが、今年は昨年同様、オンラインでの開催となり、26都道府県から115名の女子中高生が参加した(詳細は以下のURLを参照)。
http://natsugaku.jp/category/夏学2022/
日本農芸化学会からは恩田真紀(大阪公立大学 理学研究科 准教授)と、中高生と世代が近いロールモデルとして鈴木仁子 氏(東京大学 農学部 応用生命科学課程 学部4年)、若手女性研究者のロールモデルとして吉田彩子 博士(東京大学大学院 農学生命科学研究科 助教)、オブザーバーとして小倉由資 博士(東京大学大学院 農学生命科学研究科 准教授)、八波利恵 博士(東京工業大学 生命理工学院 准教授)が参加し、「ポスターとキャリア相談 “研究者・技術者と話そう”」に出展した。このプログラムは、学協会・企業(45団体)がZoomのブレイクアウトルームに分かれてプレゼンテーションを行い、それぞれの分野の魅力を伝えると共に、進路相談を行うものである。
日本農芸化学会は「身近で役立つバイオの主役!農芸化学」と題し、酵素・微生物実験を書画カメラで演示しつつ、スライド資料を用いて、農芸化学の特徴と魅力、およびジュニア農芸化学会について紹介した。
その後、生徒達との質疑応答となったが、ここでは鈴木氏の的確なアドバイスが光った。
「理科の選択が物理・化学だが(生物を履修していないが)、農学部に進学しても大丈夫か?」等の定番の質問から、「工学部のバイオ系の研究室と農学部の違いは何か?」という鋭い問いかけまで、高校時代に物理・化学を選択し、大学入学後に農学/工学の進学選択を経験した鈴木氏の経歴が大いに活かされた。また、「東大の雰囲気はどうですか?」「鈴木さんは、どんな研究をされているのですか?」等、鈴木氏に憧れと親しみを込めた質問も飛び出し、生徒達と近い世代のロールモデルの重要性を改めて実感した。
「医学部と農学部で迷っている」「医学/薬学志望だが、バイオ全般に興味がある」という生徒は今年も多く訪れたが、食品メーカーが医薬品を開発・製造しているというデータや、農芸化学を専攻する学生の就職先に医薬品・化粧品企業が多くあるという統計を提示すると、強い関心を寄せていた。
前述の理科選択の戸惑いが示す通り、高校では理系志望の生徒に対し、受験機会を狭めない物理・化学の選択を勧めているようである。一方で、ウイルス、免疫、薬剤開発、PCRという言葉が毎日のように飛び交う昨今、バイオに興味を持ち、生命科学を学びたい、関連職種に就いて社会貢献したいと願う生徒が増えるのも必然であろう。農工医薬理を広くカバーする農芸化学は、この様な時流のニーズに応え得る学術分野であり、学会員が中高生と直接対話し、説明・アドバイスできる夏学の様な事業は、非常に意義のあるものである。
ただ、やはり、対面実施に戻れればという思いが今年も強まった。オンラインでは訪れる生徒数が非常に少なく、実施できる演示実験も5分の1程度で、進路選択に重要な役割を果たす保護者や教諭に農芸化学の魅力を伝える機会が全く持てなかった。また、夏学スタッフの学部生や院生、他の学会員との交流も図れず、ブレイクアウトルームの閉じた空間で、模索しながらの展示・相談会となった。
主催者によれば、来年こそは、対面・合宿形式の「夏学」を再開させるとのこと。真夏の埼玉で、幅広い世代が交流し、熱くサイエンスを語り合えるイベントの復活が待たれる。
大阪公立大学
恩田真紀












































